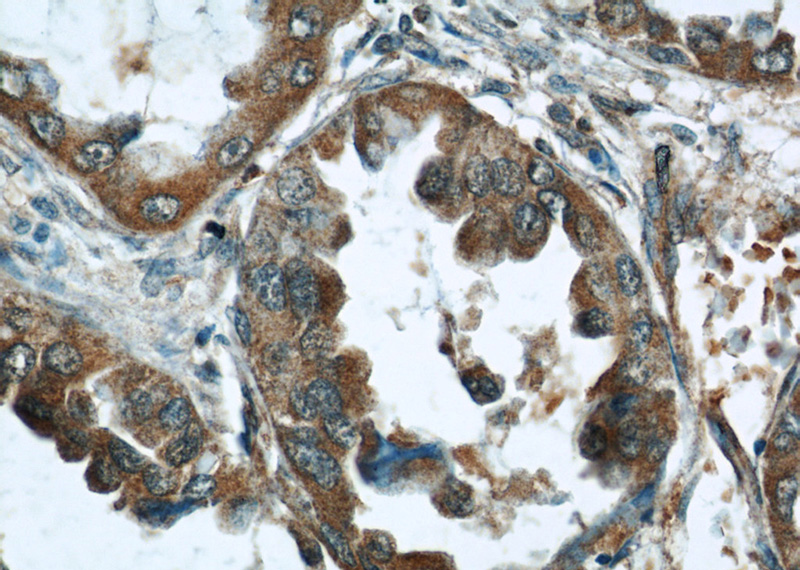
Immunohistochemical of paraffin-embedded human lung cancer using Catalog No:107606(STAT3 antibody) at dilution of 1:50 (under 40x lens)

-
Product Name
STAT3 antibody
- Documents
-
Description
STAT3 Mouse Monoclonal antibody. Positive IP detected in HeLa cells. Positive WB detected in Hela cells, Jurkat cells, RAW 264.7 cells. Positive IHC detected in human lung cancer tissue, human breast cancer tissue, human cervical cancer tissue, human heart tissue, human liver tissue. Positive IF detected in HepG2 cells. Observed molecular weight by Western-blot: 88 kDa
-
Tested applications
ELISA, WB, IHC, IP, IF
-
Species reactivity
Human,Mouse, Rat; other species not tested.
-
Alternative names
Acute phase response factor antibody; APRF antibody; FLJ20882 antibody; HIES antibody; STAT3 antibody
-
Isotype
Mouse IgG2a
-
Preparation
This antibody was obtained by immunization of STAT3 recombinant protein (Accession Number: XM_017024975). Purification method: Protein A purified.
-
Clonality
Monoclonal
-
Formulation
PBS with 0.02% sodium azide and 50% glycerol pH 7.3.
-
Storage instructions
Store at -20℃. DO NOT ALIQUOT
-
Applications
Recommended Dilution:
WB: 1:500-1:5000
IP: 1:1000-1:10000
IHC: 1:20-1:200
IF: 1:50-1:500
-
Validations

HeLa cells were subjected to SDS PAGE followed by western blot with Catalog No:107606(STAT3 antibody) at dilution of 1:1000
Immunohistochemical of paraffin-embedded human lung cancer using Catalog No:107606(STAT3 antibody) at dilution of 1:50 (under 40x lens)

IP Result of anti-STAT3 (IP:Catalog No:107606, 5ug; Detection:Catalog No:107606 1:2000) with HeLa cells lysate 1400ug.

Immunofluorescent analysis of (10% Formaldehyde) fixed HepG2 cells using Catalog No:107606(STAT3 Antibody) at dilution of 1:100 and Alexa Fluor 488-congugated AffiniPure Goat Anti-Mouse IgG(H+L)
-
Background
Signal transducer and activator of transcription 3 (acute-phase response factor) (STAT3, synonyms: APRF, FLJ20882, MGC16063) is a member of the STAT protein family. In response to cytokines and growth factors, STAT family members are phosphorylated by the receptor associated kinases, and then form homo- or heterodimers that translocate to the cell nucleus where they act as transcription activators. STAT3 is activated through phosphorylation in response to various cytokines and growth factors including IFNs, EGF, IL5, IL6, HGF, LIF and BMP2. STAT3 mediates the expression of a variety of genes in response to cell stimuli, and thus plays a key role in many cellular processes such as cell growth and apoptosis. The small GTPase Rac1 has been shown to bind and regulate the activity of STAT3. This antibody is a mouse monoclonal antibody raised against residues near the N terminus of human STAT3.
-
References
- Wang SJ, Cui HY, Liu YM. CD147 promotes Src-dependent activation of Rac1 signaling through STAT3/DOCK8 during the motility of hepatocellular carcinoma cells. Oncotarget. 6(1):243-57. 2015.
Related Products / Services
Please note: All products are "FOR RESEARCH USE ONLY AND ARE NOT INTENDED FOR DIAGNOSTIC OR THERAPEUTIC USE"
